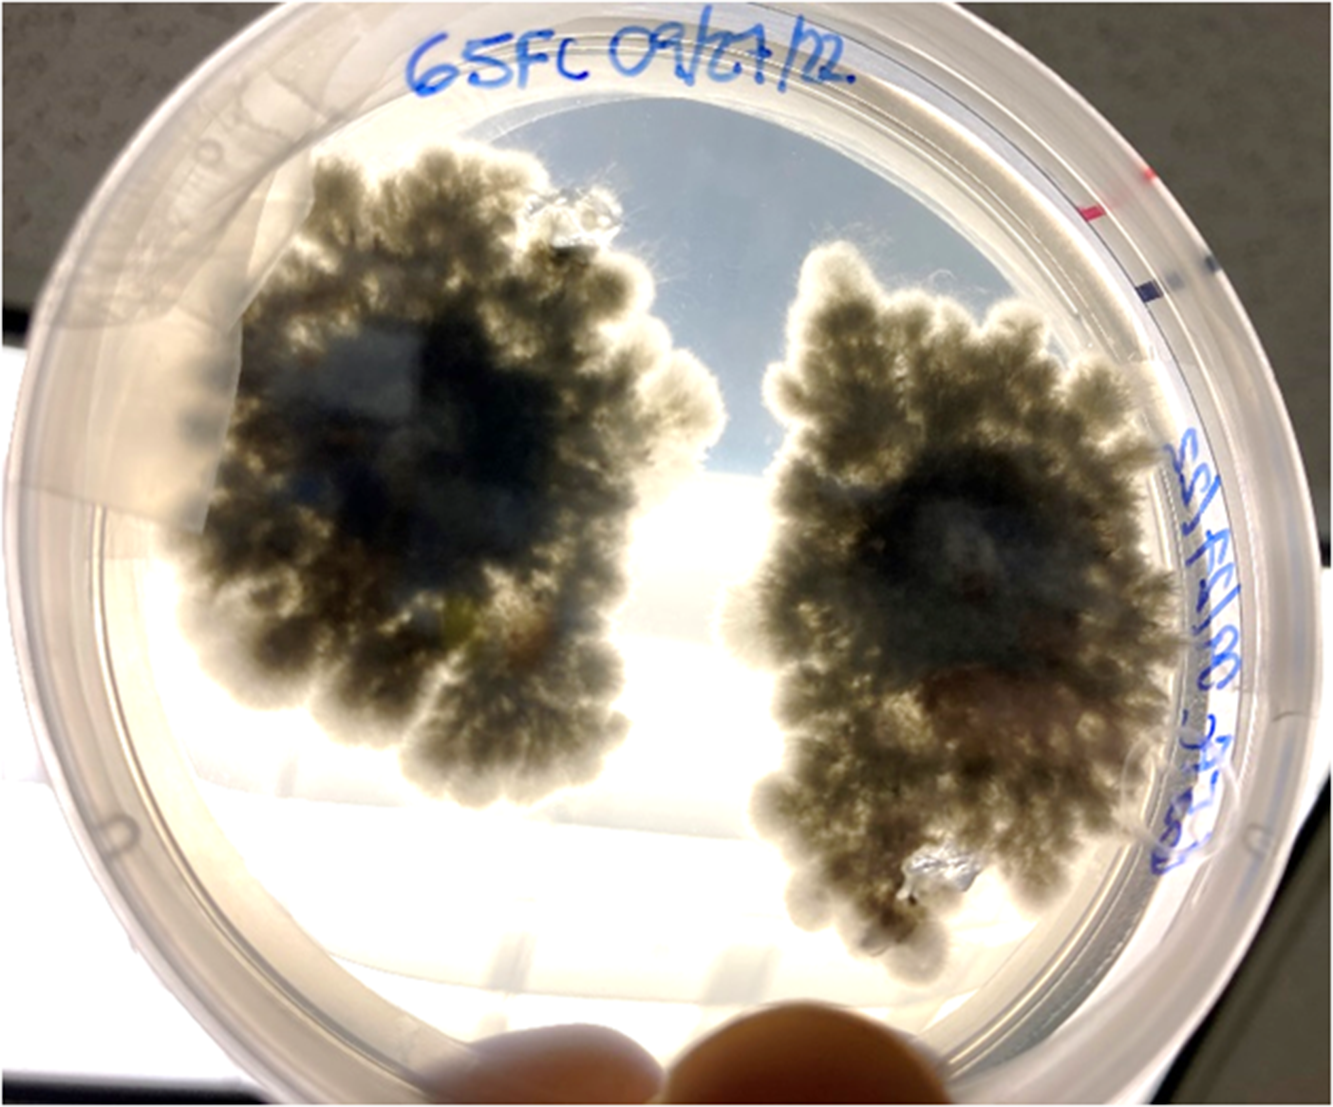

Management Implications
Schinus terebinthifolia (Brazilian peppertree) is a highly invasive woody shrub or multitrunked small tree that has invaded parts of Florida, coastal Texas, southern California, Hawaii, and Australia. Management of this weed primarily relies on costly chemical and mechanical treatments that only provide short-term control and are limited to accessible areas. A biological control program has been implemented to aid in controlling this weed, and the thrips Pseudophilothrips ichini was approved for release in Florida in 2019. Biological control of invasive plants has demonstrated efficacy and safety and can lessen the amount and frequency of herbicide use. The success of biological control agents depends on a variety of factors in the adventive range, and we focus here on understanding how multitrophic interactions between the target plant, its insect agent, and a naturally occurring stem gall–inducing fungus can potentially influence the success of the biological control program. The first step accomplished herein was confirming the identity of the fungal pathogen and demonstrating a controlled method to inoculate naive plants for future experiments. Moving forward, understanding how galling impacts agent performance will guide the biological control program. If the agent and pathogen work synergistically to damage the target weed, we would recommend targeting thrips releases on galled stands of the plant. Conversely, if there is an antagonistic effect wherein galling reduces thrips efficacy, we would recommend targeting thrips releases on uninfected stands. Furthermore, we predict the pathogen may be spread in the field via contaminated pruning equipment, and this may play a role in how biological control is integrated into management strategies.
Introduction
Brazilian peppertree (Schinus terebinthifolia Raddi, Sapindales: Anacardiaceae) is a woody shrub or multibranched small tree native to Brazil, Argentina, Paraguay, and Uruguay (Barkley Reference Barkley1944) and was introduced as an ornamental plant in the United States in the mid-1800s (Mack Reference Mack1991). After it escaped cultivation, likely due in part to a lack of effective natural enemies and pathogens, it eventually became one of the most widespread invasive plants of both natural and urban environments in Florida, USA (Rodgers et al. Reference Rodgers, Pernas and Hill2014; Schmitz Reference Schmitz1997). Since May 2019, a classical biological control agent, Pseudophilothrips ichini (Thysanoptera: Phlaeothripidae), has been released at field sites throughout Florida. While conducting surveys at release sites, we noted several instances of galls on the stems of the plant, many of which manifested as witch’s broom–like growths. Similar galls were subsequently noted in potted S. terebinthifolia saplings in our nursery plots used to mass rear P. ichini colonies for research and for field release onto natural infestations of S. terebinthifolia. Literature on S. terebinthifolia galls is limited, but a published report identified Sphaeropsis tumefaciens (Botryosphaeriaceae) as a gall-inducing fungus in S. terebinthifolia (Marlatt and Ridings Reference Marlatt and Ridings1979). The galls reported in the latter resemble swollen, woody stem nodules that can manifest into witch’s broom–like growths as multiple stems arise from the galls. These closely resemble the galls studied herein.
Fungi in the family Botryosphaeriaceae are typically endophytes that are hosted by a variety of woody plant species (Slippers and Wingfield Reference Slippers and Wingfield2007), some of which behave as opportunistic pathogens when the host plants are environmentally, mechanically, or chemically stressed (Rayachhetry et al. Reference Rayachhetry, Blakeslee and Center1996; Schoeneweiss Reference Schoeneweiss1981). In addition to S. terebinthifolia, other hosts in Anacardiaceae include pistachios (Pistacia vera L.) (Michailides and Morgan Reference Michailides and Morgan1993), mango (Mangifera indica L.) (Li et al. Reference Li, Mohd, Mohamed Nor, Subramaniam and Latiffah2021; Puig and Winterstein Reference Puig and Winterstein2021; Sakalidis et al. Reference Sakalidis, Ray, Lanoiselet, Hardy and Burgess2011; Trakunyingcharoen et al. Reference Trakunyingcharoen, Cheewangkoon, To-Anun, Crous, Van Niekerk and Lombard2014), and cashew (Anacardium occidentale L.) (Netto et al. Reference Netto, Lima, Correia, Da Silva, Thon, Martins, Miller, Michereff and Câmara2017). Spores or hyphal fragments can infect and colonize hosts through wounds (Smith et al. Reference Smith, Kemp and Wingfield1994) or even through natural openings like stomata and lenticels (Brown and Hendrix Reference Brown and Hendrix1981; Kim et al. Reference Kim, Park and Ahn1999; Smith et al. Reference Smith, Kemp and Wingfield1994). The natural spread of spores may be enhanced locally by raindrops splashing during wet seasons, which may help spores adhere to plant surfaces (Slippers and Wingfield Reference Slippers and Wingfield2007).
The potential for further stress imposed by the addition of the S. terebinthifolia biological control agent necessitates an understanding of this novel plant–insect–fungus system. There is no new evidence to suggest the galls can control S. terebinthifolia (Marlatt and Ridings Reference Marlatt and Ridings1979), and no studies have been conducted to understand how the galls may affect biological control agent behavior or effectiveness. Galls in other systems can divert plant resources and serve as nutrition sinks (Harris and Shorthouse Reference Harris and Shorthouse1996), and here the quality of the infected host as a nutritional food source for the thrips agent will need to be understood. Given more recent genetic research on the taxonomy of the Botryosphaeriaceae (Mohali-Castillo Reference Mohali-Castillo2023; Taylor et al. Reference Taylor, Jacobson, Kroken, Kasuga, Geiser, Hibbett and Fisher2000; Zhou and Stanosz Reference Zhou and Stanosz2001), our first objective was to determine whether S. tumefaciens or a different agent was responsible for the development of galls in S. terebinthifolia, both on mature trees at field sites and on saplings in our nursery plots. Our second objective was to demonstrate a method to infect plants that can be used in future studies with controlled experiments to further investigate this plant–insect–fungus interaction.
Materials and Methods
Gall Tissue Sample Collection
Live branches with galls were collected from mature S. terebinthifolia plants at a field site in Broward County, FL, USA (25.95725°N, 80.40788°W). Galls on these mature trees were up to 10 cm in diameter (Figure 1). We sampled branches roughly 3 cm in diameter, transported them to the laboratory, and harvested 1- to 3-cm-diameter galls that were still covered with green bark. Gall tissues inside green bark were still live and were composed of hypertrophied sapwood.

Figure 1. Large 10-cm-diameter galls and witch’s broom–like growth on a dead branch from a mature Schinus terebinthifolia in the field.
Field galls that had minimal or no necrotic stems emerging from their surfaces were selected for extracting woody tissues, surface sterilized by brief immersion in 70% ethanol, and quickly flamed over a Bunsen burner in a sterile Purifier Class II Biosafety Cabinet (Labconco, Kansas City, MO, USA). Galls were then split open, and samples of small pieces (ca. 4 by 1.5 mm) of woody tissue were excised from the base of the galls’ points of attachment to the main branch that often had discolored (undecomposed light brown) sapwood. There were three types of sample tissues: (1) black/gray and heavily lignified (B), (2) partially discolored/intermediate (+), and (3) white, non-discolored (W). Between each dissection, tools were wiped clean with 100% ethanol and quickly flamed over a Bunsen burner in the biosafety cabinet.
We also aimed to collect gall tissue samples for DNA extraction to identify the fungal agent. First, gall tissues were taken from a single field-collected branch and were subdivided into the B, +, and W tissue sections. Second, we sought to confirm that the same fungal agent was responsible for galls on our potted nursery saplings. We chose five potted saplings from nursery stock at the USDA-ARS Invasive Plant Research Laboratory (IPRL) in Fort Lauderdale, FL, USA (26.08433°N, 80.24045°W), with galls very similar to those observed at the field sites. Branches with galls trimmed from potted plants were around 1 cm in diameter, and gall sizes were like those recovered from field sites. Galls that were earlier in their progression but still distinct were selected for dissection and extraction of infected woody tissue as previously described.
Isolation and Purification of the Gall Fungus
Galls from the nursery stock plants were used as sources of infected tissue for isolation and purification of the fungus. Small pieces (4 by 1.5 mm) of partially discolored (+) gall tissue were surface sterilized with 70% ethanol and quickly flamed over a Bunsen burner in the biosafety cabinet. Standard potato dextrose agar (PDA) (Becton, Dickinson, Franklin Lakes, NJ, USA) and acid-PDA (APDA, 42.5% solution of lactic acid known to suppress bacterial growth) plates were prepared in 9-cm-diameter plastic petri dishes (Fisher Scientific, Hampton, NJ, USA). Subsequently, out of eight disinfected gall pieces from an individual harvested gall, two samples were placed on each PDA plate, and two samples were added to an APDA plate, with two replicates for each plate. Plates were kept in a completely dark incubator at 27 C, which was closest to mean outdoor and laboratory temperatures and within the range of incubation temperatures reported elsewhere (Adeniyi et al. Reference Adeniyi, Animasaun, Oduoye and Krishnamurthy2020). One week after the initial plating, we removed 5-mm-diameter core punches from the leading edges of colonies and placed one punch in the center of a new APDA plate. This method was used because colonies were morphologically uniform, and repeated transfer yielded the same morphospecies. Fungal hyphae originating from the gall tissue of four saplings were subsampled from colonies on the isolate plates for DNA extraction.
Naive Plant Inoculation
Schinus terebinthifolia saplings were produced from seed in November 2021, following the plant production protocol of Halbritter et al. (Reference Halbritter, Rayamajhi, Wheeler, Leidi, Owens and Cogan2021). In October 2022, plants were treated with the systemic fungicide myclobutanil at 4.75 ml L−1 (19.7% v/v; Eagle 20EW, Corteva Agriscience, Indianapolis, IN, USA), pruned, treated with the ready-to-use contact fungicide copper octanoate (0.08% v/v; Captain Jack’s Copper Fungicide, Bonide, Oriskany, NY, USA), and moved into a glasshouse. The systemic fungicide was applied before pruning to maximize translocation, and the contact fungicide was applied after pruning to minimize infections at cut sites. Maintenance pruning, irrigation, fertilization, and insecticidal soap application continued as in Halbritter et al. (Reference Halbritter, Rayamajhi, Wheeler, Leidi, Owens and Cogan2021). As an extra measure to minimize arthropod pest presence after fungal inoculation, we began applying two systematic pesticides, acephate at 7.9 ml L−1 (9.4% v/v; Systemic Insect Control II, Bonide) and abamectin at 0.3 ml L−1 (2.0% v/v; Avid 0.15EC Miticide/Insecticide, Syngenta, Greensboro, NC, USA), to plants monthly starting in February 2023, with the last application in May 2023 before plants were used for a separate laboratory experiment.
Two isolate plates with the same clonal colonies originating from the same plant were used as the source of inoculum for 25 plants in January 2023, when plants had flushing new stem growth roughly 10- to 20-cm long. Five woody branches were selected on each plant to receive inoculations. Each inoculation point was such that there were no other points distal to it on the same branch. Each branch selected was at least 5 mm in diameter. Inoculation methodology was largely based on Marlatt and Ridings (Reference Marlatt and Ridings1979), with some modifications. Each point received two 5-mm-diameter punches of mycelial mats from the APDA dish isolates of the most abundant morphologically distinct morphospecies. Excess APDA was carefully scraped off the undersides of the punches. Each inoculation point (i.e., wound) was created by scraping the bark with sandpaper down to the white woody tissue, leaving a roughly 1-cm patch of wood exposed and an additional 0.5 cm of green cambium exposed on either side. Wounds were made within 5 mm of a node bearing vegetation. Two punches were placed topside down and lengthwise along the stem onto each fresh wound to cover the scraped area and immediately wrapped with two 1.5 by 5 cm single-ply strips of cotton cheesecloth that had been dampened with 500 µl of autoclaved distilled deionized water. The cloth was then wrapped with 1-cm-wide masking tape to completely cover and hold it in place. Fifteen control plants were wounded and wrapped in the same manner but without fungal inoculation.
Plants were loosely covered in plastic bags and left undisturbed on the lab bench for 2 d, and then uncovered and returned to the glasshouse (average conditions: 28.6 C, 66.8% relative humidity). After 1 mo, cloth covers were removed from wound sites, and healing was evident in most plants. Bark had grown inward, meeting in a line at the center of most wounds. Pruning, irrigation, fertilization, and insecticidal soap application continued as before, but stems were not pruned within 5 cm of a wound site. Inoculated and control plants were kept on separate benches in the glasshouse. When galls had formed, gall tissue was sampled for DNA analysis from five of the plants (labeled as 10+, 15+, 16+W, 21+,22+) using the procedure described earlier, except most galls yielded too little tissue to separate by degree of discoloration and were pooled as the + category.
DNA Extraction, PCR Amplification, and Sequencing
Woody tissue samples from field and inoculated galls and fungal hyphae from isolate plates as described earlier were placed into 1.5-ml vials and stored in a −20 C freezer. DNA was extracted using the DNeasy Plant Mini Kit (Germantown, MD, USA) from approximately 50 mg of dissected gall tissue or fungal hyphae. The ITS1 region between the small nuclear 18S rDNA and large nuclear 28S rDNA was amplified and sequenced using the universal fungal primers presented in Stielow et al. (Reference Stielow, Levesque, Seifert, Meyer, Irinyi, Smits, Renfurm, Verkley, Groenewald and Chaduli2015). The ITS4-F and ITS5-R primers were used throughout; however, for the inoculated gall tissue, the ITS1-F primer was also used. The ITS1-F primer anneals 3 bp beyond the end of ITS5-F and was added to increase fungal specificity given the presence of host tissue in samples. PCR reaction conditions were carried out in a 50-μl reaction using 3U G-Biosciences (St Louis, MO, USA) Taq polymerase, 1X reaction buffer, 1.1 mM added MgSO4, 0.2 mM dNTPs, and 0.3 mM each primer. Apart from the hyphal samples, DNA quantification could not reveal the amount of fungal DNA. As such, a dilution series was set up using the 100 µl of DNA eluent and dilutions of 1:10, 1:100, and 1:1,000 in water. These four levels were subjected to a gradient reaction from 53 C through 58 C. PCR product was produced at dilution levels from 1X through 1:100, although amplification at the 1:100 level was weak. Amplifications were then carried out using either 1X or 1:10X DNA. Amplification products were produced throughout the gradient temperature range, although amplification at 58 C was weak. Following this screening step, amplifications were carried out using an initial denaturation of 98 C for 45 s, followed by 35 amplification cycles (denaturation, 94 C, 1 min; annealing, 57 C, 1 min; extension, 72 C, 2 min) and a final extension at 72 C for 7 min. Due to amplification problems with some hyphal samples, perhaps due to residual agar in the DNA extractions and low template concentrations, the template was rapidly consumed. GenomiPhi V2 (Cytiva, St Louis, MO, USA) was subsequently used to increase the remaining template following the manual specifications, but at one-third the volumes. Subsequently, 24 µl of water was added, bringing the final volume to 30 µl. Half this was then subjected to a 1:10 dilution with water. PCR was then carried out as previously described using both fractions as genomic.
Two bands appeared in the 1.5% agarose gels of the gall PCRs, one at about 750 bp and the other at about 600 bp. The bands were excised from the gel and cleaned using the E.Z.N.A. Gel Extraction Kit (Omega Bio-tek, Norcross, GA, USA). Sanger sequencing was then conducted by McLab (South San Francisco, CA, USA). Sequences were reviewed using Sequencher (Gene Codes, Ann Arbor, MI, USA), exported as fasta files, and then referenced using NCBI BLASTn (megablast) (see https://doi.org/10.1017/inp.2024.3).
Results and Discussion
Fungal colonies began to grow in fewer than 7 d, and the predominant morphospecies had aerial mycelia on the surface of the growth media that were raised, fluffy, and initially white but melanized to a dark greenish black (from above) with age. Submerged mycelia (reverse) were turning from white to olivaceous to greenish black with age (Figure 2), similar to those reported as S. tumefaciens in Marlatt and Riddings (1979). We noticed two obvious morphospecies here, and the predominant morphospecies grew from all five nursery gall inocula. The second, less abundant morphospecies only came from one plant’s gall tissue and had a denser mycelial mat that remained white. These fungal colonies were present in both PDA and APDA plates.
Figure 2. Two colonies of Cophinforma sp. 8 d after excision and placement of two gall tissue samples collected from a stem of Schinus terebinthifolia onto an acidic potato dextrose agar plate.
Three fungal isolates from the predominant morphospecies were randomly selected (pool of 32 duplicate isolates) and sequenced, producing a contig of 577 bases. These isolates were identified in National Center for Biotechnology Information (NCBI), as being from the initial field gall, as Cophinforma mamane/atrovirens with an identity match of 100% using BLASTn. The second, less abundant morphospecies (only two duplicate isolates) produced a sequence 543-bp long, which had 100% identity as Neopestalotiopsis maddoxii in NCBI. This is likely to have been a contaminant of gall tissue with some degree of rot. Neopestalotiopsis maddoxii is one of a suite of Neopestalotiopsis species associated with both macadamia nut (Macadamia integrifolia Maiden & Betche) flower diseases (Prasannath et al. Reference Prasannath, Shivas, Galea and Akinsanmi2021) and gray leaf spot in Mangifera indica (Gerardo-Lugo et al. Reference Gerardo-Lugo, Tovar-Pedraza, Maharachchikumbura, Apodaca-Sánchez, Correia, Sauceda-Acosta, Camacho-Tapia, Hyde, Marraiki and Elgorban2020), indicating it is a generalist, because it infects species both in the Proteaceae and Anacardiaceae. Of recent concern are serious outbreaks of a fungal disease on strawberries (Fragaria ×ananassa Duch., Rosaceae) in Florida commercial fields that have been reported as producing severely diminished yields (Baggio et al. Reference Baggio, Forcelini, Wang, Ruschel, Mertely and Peres2021). Initial isolates recovered in the latter study were identified as Neopestalotiopsis rosae, displaying pale luteous to orange coloration when viewed from the bottom. However, a new and more virulent Neopestalotiopsis spp. is characterized by white to pale yellow colonies, similar to the appearance of the second, less abundant morphospecies in our cultures. It would be of interest to discern whether the Neopestalotiopsis outbreaks are more likely to occur near S. terebinthifolia populations.
Small galls (∼5 mm) first became apparent on roughly 20% of plants 2 mo after plants received the purified hyphal inoculum. By 6 mo, galls had developed on 92% of the inoculated plants (Figure 3). For two plants, galling occurred at every wound site, but most plants had a gall at 2/5 to 4/5 wound sites per plant. The largest gall was 14 by 8 by 6 mm. Distal stem flagging, as indicated by rapid stem dieback with dead leaves remaining attached, was noted beyond galls as early as 4 mo postinoculation, and some galls had killed the entire branch they resided on by 6 mo postinoculation. No galls developed on control plants.

Figure 3. Galls on Schinus terebinthifolia stems 6 mo after inoculation from cultured mycelial mats placed onto stem abrasions.
As noted earlier, the DNA extractions from the infected young S. terebinthifolia plants/galls also produced the two bands. However, while the resequenced S. terebinthifolia (∼750 bp) band strongly amplified, the fungal band (∼600 bp) was very weak. It was here that the ITS1 primer was introduced, and the ITS1/ITS4 combination seemed to slightly improve the yield. Nevertheless, for each of the inoculated plant gall extractions, large numbers of reactions and gel extractions were required, still mostly producing only enough product for a unidirectional sequence. The 10+ gall sequence (unidirectional, ITS5 primer) was 509 bp in length. The 15+ sequence (unidirectional, ITS1 primer) was 536 bp. The 16+W sequence (unidirectional, ITS1 primer) was 472 bp. The 21+ sequence (unidirectional, ITS4 primer) was only 211 bp. Finally, 22+ produced enough product for a bidirectional sequence (ITS4/ITS5) of 536 bp. When a BLASTn was conducted for each in NCBI, all five sequences produced a 100% identity to C. mamane/atrovirens. When 84 ITS1 sequences of Cophinforma were downloaded and curated from NCBI, 77 were identical regardless of the species. However, there were three C. mamane in a separate clade differing by 1 bp, and three C. atrovirens in a separate clade differing by 2 bp. We suspect that these samples represent the variation in a single species.
Phillips et al. (Reference Phillips, Alves, Abdollahzadeh, Slippers, Wingfield, Groenewald and Crous2013), in a review of the Botryosphaeriaceae, noted that the two species previously included in Botryosphaeria are better accommodated in Cophinforma, of relevance because some of the identifying accessions in NCBI contained the earlier designation. They also showed C. atrovirens sequences as identical to Cophinforma eucalypti and considered them to represent a single species. They described the colonies as “fluffy, initially white to olivaceous in the center, edges becoming olivaceous to greenish black with age,” a description similar to ours. On the other hand, they consider C. mamane and C. atrovirens as two distinct species (differing by 3 bp in ITS1). Indeed, our sequences show a BLASTn of 100% to the ITS1 sequence of MH863428, the holotype for C. atrovirens. However, the conclusions Phillips et al. (Reference Phillips, Alves, Abdollahzadeh, Slippers, Wingfield, Groenewald and Crous2013) made on species differences seem uncertain. A brief survey at the top of the BLASTn results (using our field gall sequence) matches that of C. mamane specimens on Eucalyptus urophylla S. T. Balke and cacao (Theobroma cacao L.) in Venezuela (KF531822, KU377487), Mangifera indica in China (OP910085), Malabar plum [Syzygium jambos (L.) Alston] in Sumatra (OM746695), Eucalyptus in South Africa (EF118052), and tea [Camellia sinensis (L.) Kuntze] in Sri Lanka (KM406105). Further taxonomic research is needed to resolve the C. mamane/atrovirens species identification.
We have shown here that stem galls observed on S. terebinthifolia can result from fungal infection by the Cophinforma sp. isolated in this study. We have successfully transferred the fungus from infected plants to naive plants, resulting in disease symptoms in the latter. This was achieved with mycelial fragments without spores, as sporulation was not observed in culture plates in the timeline of this study. Given revisions within the Botryosphaeriaceae using DNA barcodes (Mohali-Castillo Reference Mohali-Castillo2023; Moral et al. Reference Moral, Morgan, Trapero and Michailides2019; Taylor et al. Reference Taylor, Jacobson, Kroken, Kasuga, Geiser, Hibbett and Fisher2000; Zhou and Stanosz Reference Zhou and Stanosz2001), including the ITS used herein, and based on similarities of the galls, S. tumefaciens described as a host in S. terebinthifolia by Marlatt and Ridings (Reference Marlatt and Ridings1979) may have been this Cophinforma species.
It is possible that wounds inflicted by pruning shears as part of our routine plant maintenance had spread the fungus to other plants, even while they are not sporulating. Similarly, heavy machinery used by stakeholders in the mechanical removal or trimming of S. terebinthifolia may be spreading the gall fungus or causing new infection sites on trimmed trees. We have noted the presence of galls at many sites in urban areas and parks, where such pruning operations are more routine (DAH, personal observation). Not surprisingly, humans have been implicated in the long-distance dispersal of Botryosphaeriaceae (Slippers et al. Reference Slippers, Crous, Jami, Groenewald and Wingfield2017; Slippers and Wingfield Reference Slippers and Wingfield2007). Given that S. terebinthifolia galls can also host Neopestalotiopsis, which can occur in a wide range of plant hosts (see Santos et al. Reference Santos, Mafia, Aguiar, Zarpelon, Damacena, Barros and Ferreira2020: table 1), studies are needed to confirm whether galled S. terebinthifolia infestations adjacent to strawberry fields could harbor the pathogen.
While there remains no new evidence to suggest the galling of S. terebinthifolia is sufficient to control the plant (Marlatt and Ridings Reference Marlatt and Ridings1979), multitrophic interactions between the plant, fungus, and thrips biological control agent warrant future research given that stressors can manifest disease symptoms in infected plants (Schoeneweiss Reference Schoeneweiss1981). Other gall inducers have been successfully implemented as biological control agents targeting a variety of plant species (Dennill Reference Dennill1985; Harris and Shorthouse Reference Harris and Shorthouse1996; Sarratt et al. Reference Sarratt, Perryman and Pratt2023), and although Cophinforma is not a classical biological control agent, its potential to negatively impact S. terebinthifolia should not be dismissed. We noted shoot death beyond galls and have seen shoot death emanating from galls in the field, and this warrants new studies of the galls’ impact on S. terebinthifolia growth and reproduction. Future work should also investigate the potential for additive or synergistic interactions between the thrips agent and the fungus in enhancing the impact of the biological control program, where infected plants may be more vulnerable to thrips attack and vice versa. The demonstrated ability here to experimentally inoculate plants builds on the work by Marlatt and Ridings (Reference Marlatt and Ridings1979) and can be used in future research in this biological system.
Supplementary material
To view supplementary material for this article, please visit https://doi.org/10.1017/inp.2024.3
Acknowledgments
We thank Laura Cash, Jenna Owens, Carly Cogan, and Nicholas Vallone for their work to produce, maintain, and prepare the potted nursery plants for this study. This work was partially funded by the South Florida Water Management District and U.S. Army Corps of Engineers as part of the Comprehensive Everglades Restoration Plan and by the U.S. Department of Agriculture–Agricultural Research Service. Mention of trade names or commercial products in this publication is solely for the purpose of providing specific information and does not imply recommendation or endorsement by the USDA. USDA is an equal opportunity employer and provider. No competing interests have been declared.